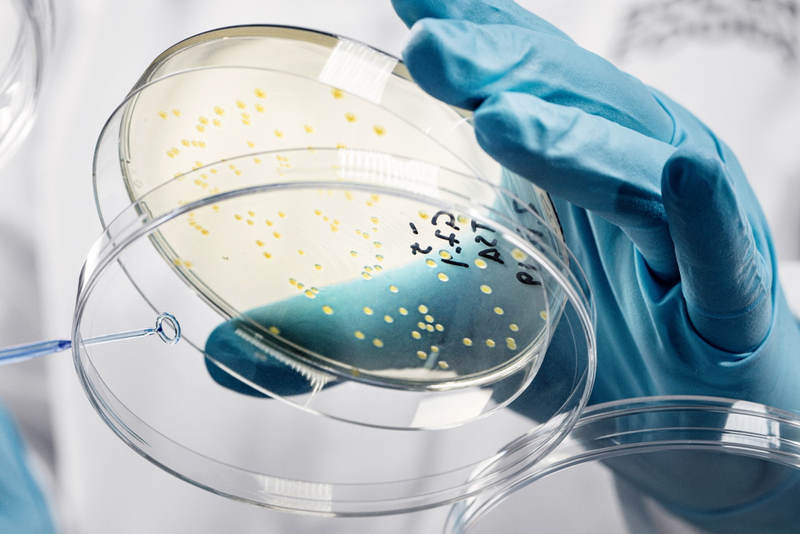
图片

用空气“无中生肉”的合成生物企业,要上市了 2024年7月21日
你相信吗?利用合 成生物技术,人类能“凭空”制 造食物。 这种技术叫微生物发酵蛋白,是替代蛋白产业的一个分支,简单概括,就是 通过空气和电力培养细胞,并生成蛋白质。 芬兰初创公司 Solar Foods 就是这一领域的先驱,近日 该公司宣布,正计划在赫尔辛基证券交易所进行技术上市。 在相关媒体的采访中,首席执行官兼联合创始人Pasi Vainikka 没有给出确切的时间表,但表示这将是“几个月的事情”。
相当于拥有300头奶牛的牛场
Solar Foods成立于2017年,是芬兰VTT技术研究中心和LUT大学的分拆公司,成立至今已完成了 3000多万美元 的融资。 该公司的核心技术,是使用二氧化碳和氢气代替糖来喂养细菌。 该技术比起传统动物畜牧业具有明显的环境效益, 不仅 排放更低 , 水 和土地资源用量更少 ,还为工厂增添了更靠近终端消费者的可能性。
在今年四月,全球首个大规模空气蛋白生产设备, Solar Foods 位于赫尔辛基的01工厂开始生产,产能高达160吨,蛋白质产量相当于拥有300头奶牛的牛场 。 在官方的表述中,这个工厂的前端类似于炼油厂,中间部分像啤酒厂,下游部分像乳制品工厂。 在通过电解来获得氢气后(使用电力将水分解成氢气和氧气的组成部分),通过发酵罐 凭 空制造食物。 在相关资质方面,该公司已在新加坡获得新型食品批准,计划在今年于美国提交GRAS认证,EFSA(欧洲食品安全局)的相关资质审批也在同步进行中。
目前Solar Foods已经筹集了约4700万美元的股权和约3200万美元的债务融资。 并且已经有3620万美元的欧洲共同利益重要项目( IPCEI)赠款用于01号工厂,以及7600万欧元(8100万美元)的02号工厂赠款。
空气蛋白的中国力量
实际上,让二氧化碳变“废”为“宝”的技术,我国同样处于领先地位。
2021年9月,中国科学院天津工业生物技术研究所马延和团队 首次在实验室实现了二氧化碳到淀粉的合成,被称为”空气变馒头“,引起全球轰动。
2022年,由 电子科技大学夏川课题组、中国科学院深圳先进技术研究院于涛课题组与中国科学技术大学曾杰课题组 共同完成的研究表明。 通过电催化结合生物合成的方式,将二氧化碳高效还原合成高浓度乙酸,进一步利用微生物可以合成葡萄糖和脂肪酸。 在产业界,利用微生物将甲烷转化为蛋白质的美国公司 Calysta 与北京 首钢朗泽 等企业合资建立的 恺迪苏 在重庆落地,相关产品已在中国获批作为水产饲料,已完成首批交付。
去年5月 ,昌进生物 发布了中国首款用微生物发酵制成的乳制品,首条微生物蛋白生产线已在青岛投产。 吉态来博 攻克了无机碳源(CO₂、CO)转化为有机产品的产业难题,实现了 以CO₂和H₂为原料生产高性能蛋白的全过程。
目前,验证结果达到每3200标方合成气和1~2吨CO₂便可以转化成1吨酵母蛋白,其经济价值达到1.2~1.3万元/吨,远高于传统CO₂转化甲醇的经济价值。 上述种种突破,为人类解决地球“粮食危机”和“气候危机”提供了一条新途径,也打开了广阔的市场空间。 —The End—